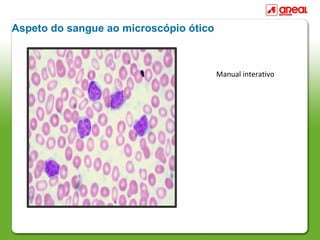
Aspeto do sangue ao microscópio ótico



                                        Manual interativo

O documento descreve o sistema circulatório e a circulação sanguínea no corpo humano. Resume-se em 3 frases:
O sistema circulatório é constituído pelo coração e vasos sanguíneos, e tem como função transportar o sangue por todo o corpo. O sangue contém glóbulos vermelhos, brancos e plaquetas suspenso no plasma. O coração bombeia o sangue através de uma circulação dupla - pulmonar e sistêmica - para fornecer oxigênio e nutrientes a todas as células.